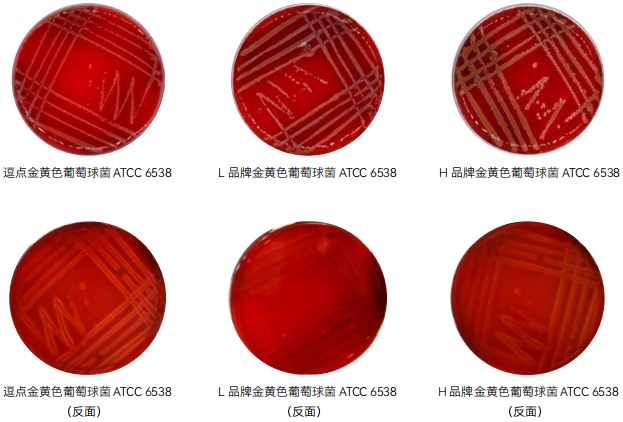

金黄色葡萄球菌平板计数法检验程序见图 2。
1、操作步骤
1.1 样品的稀释
1. 固体和半固体样品 : 称取 25g 样品置于盛有 225mL 磷酸盐缓冲液或生理盐水的无菌均质杯 内 ,8000r/min~10000r/min 均质 1min~2min, 或置于盛有 225mL 稀释液的无菌均质袋中 , 用拍 击式均质器拍打 1min~2min, 制成 1 ∶ 10 的样品匀液。
2. 液体样品 : 以无菌吸管吸取 25mL 样品置于盛有 225mL 磷酸盐缓冲液或生理盐水的无菌锥形 瓶 ( 瓶内预置适当数量的无菌玻璃珠 ) 中 , 充分混匀 , 制成 1 ∶ 10 的样品匀液。
3. 用 1mL 无菌吸管或微量移液器吸取 1 ∶ 10 样品匀液 1mL, 沿管壁缓慢注于盛有 9mL 磷酸盐 缓冲液或生理盐水的无菌试管中 ( 注意吸管或吸头尖端不要触及稀释液面 ), 振摇试管或换用 1 支 1mL 无菌吸管反复吹打使其混合均匀 , 制成 1 ∶ 100的样品匀液。
4. 按 3 操作程序 , 制备 10 倍系列稀释样品匀液。每递增稀释一次 , 换用 1 次 1mL 无菌吸管或 吸头。
1.2 样品的接种
根据对样品污染状况的估计 , 选择 2 个 ~3 个适宜稀释度的样品匀液 ( 液体样品可包括原液 ), 在进 行 10 倍递增稀释的同时 ,每个稀释度分别吸取 1mL 样品匀液以 0.3mL、0.3mL、0.4mL 接种量分别 加入三块 Baird-Parker 平板 , 然后用无菌涂布棒涂布整个平板 , 注意不要触及平板边缘。使用前 , 如 Baird-Parker 平板表面有水珠 , 可放在 25 ℃ ~50 ℃的培养箱里干燥 , 直到平板表面的水珠消失。
1.3 培养
培养 在通常情况下 , 涂布后 , 将平板静置 10min, 如样液不易吸收 , 可将平板放在培养箱 36 ℃ ±1 ℃培 养 1h; 等样品匀液吸收后翻转平板 , 倒置后于 36 ℃ ±1 ℃培养 24h~48h。
2、典型菌落计数和确认
1. 金黄色葡萄球菌在 Baird-Parker 平板上呈圆形 , 表面光滑、凸起、湿润、菌落直径为 2 mm~ 3mm, 颜色呈灰黑色至黑色 ,有光泽 , 常有浅色 ( 非白色 ) 的边缘 , 周围绕以不透明圈 ( 沉淀 ), 其外常有一 清晰带。当用接种针触及菌落时具有黄油样黏稠感。有时可见到不分解脂肪的菌株 , 除没有不透明圈 和清晰带外 , 其他外观基本相同。从长期贮存的冷冻或脱水食品中分离的菌落 , 其黑色常较典型菌落浅 些 , 且外观可能较粗糙 , 质地较干燥。
2. 选择有典型的金黄色葡萄球菌菌落的平板 , 且同一稀释度 3 个平板所有菌落数合计在 20CFU~ 200CFU 之间的平板 , 计数典型菌落数。
3. 从典型菌落中至少选 5 个可疑菌落 ( 小于 5 个全选 ) 进行鉴定试验。分别做染色镜检 , 血浆凝固酶试验 ; 同时划线接种到血平板 36℃ ±1℃培养 18h~24h 后观察菌落形态 , 金黄色葡萄球菌 菌落较大 , 圆形、光滑凸起、湿润、金黄色 ( 有时为白色 ),菌落周围可见完全透明溶血圈。
3、结果计数
1. 若只有一个稀释度平板的典型菌落数在 20CFU~200CFU 之间 , 计数该稀释度平板上的典型菌落 , 按式 (1) 计算。
2. 若最低稀释度平板的典型菌落数小于 20CFU, 计数该稀释度平板上的典型菌落 , 按式 (1) 计算。
3. 若某一稀释度平板的典型菌落数大于 200CFU, 但下一稀释度平板上没有典型菌落 , 计数该稀释 度平板上的典型菌落 , 按式 (1) 计算。
4. 若某一稀释度平板的典型菌落数大于 200CFU, 而下一稀释度平板上虽有 典型菌落但不在 20CFU~200CFU 范围内 , 应计数该稀释度平板上的典型菌落 , 按式 (1) 计算。
5. 若 2 个连续稀释度的平板典型菌落数均在 20CFU~200CFU 之间 , 按式 (2) 计算。

4、结果报告
根据上面的公式计算结果 , 报告每 g(mL) 样品中金黄色葡萄球菌数 , 以 CFU/g(mL) 表示 ; 如 T 值为 0, 则以小于 1 乘以最低稀释倍数报告。
注意要点
1. 取 1mL 样品稀释匀液接种 3 个 Baird-Parker 平板(此处并未严格按照标准中 0.3mL、0.3mL、0.4mL 精确取样,由于如此操作会增加试验时间,无法在 15min 内完成试验)。
2. 涂布时不要触及平板边缘(会导致样液涂抹不均匀,大部分汇集于边缘)。
3. 可用同一根涂布棒从低稀释度到高稀释度进行涂布(不用换涂布棒)。
4. 涂布完成后应稍微放置一段时间使培养基吸收样品匀液。
5. 若水珠较多,可正置于培养箱中 1 ~ 2h 后再倒置培养。
6.36±1℃培养 24h 后观察,有典型菌落生长则进行证实试验(革兰氏染色镜检、血浆凝固酶试验、划线血平板)。若无菌落生长则继续培养至 48h 后再观察,有典型菌落生长则进行证实试验,无典型菌落生长则试验终止。
第三法 金黄色葡萄球菌 MPN 计数
1、操作步骤
同第二法
2、接种培养
1. 根据对样品污染状况的估计 , 选择 3 个适宜稀释度的样品匀液 ( 液体样品可包括原液 ), 在进行 10 倍递增稀释的同时 , 每个稀释度分别接种 1 mL 样品匀液至 7.5% 氯化钠肉汤管 ( 如接种量超过 1mL, 则用双料 7.5% 氯化钠肉汤 ), 每个稀释度接种
3 管 , 将上述接种物 36℃ ±1℃培养 ,18h~24h。
2. 用接种环从培养后的 7.5% 氯化钠肉汤管中分别取培养物 1 环 , 移种于 Baird-Parker 平板 36℃ ±1 ℃培养 ,24h~48h。
3、典型菌落确认
同第二法
4、结果报告
根据证实为金黄色葡萄球菌阳性的试管管数 , 查 MPN 检索表 , 报告每 g(mL) 样品中金黄色葡萄球菌的最可能数 , 以 MPN/g(mL) 表示。
注意要点
1、样品稀释同菌落总数,取 3 个连续稀释度稀释液(或包括液体样品原液),每个稀释度接种 3 管 7.5% 氯化钠肉汤,每管接种 1mL,36±1℃培养 18h 后观察,若出现浑浊则接种至 Baird-Parker 平板,若无变化则继续培养至 24h 后再接种至Baird-Parker 平板。
2、划线接种至 Baird-Parker 平板,36±1℃培养 24h 后观察,有典型菌落生长则进行证实试验(革兰氏染色镜检、血浆凝固酶试验、划线血平板)。若无菌落生长则继续培养至 48h 后再观察,有典型菌落生长则进行证实试验,无典型菌落生长则试验终止。
3、根据证实后的阳性管数差 MPN 表得出结果。
三、培养基原理解析
1. 7.5% 氯化钠肉汤
蛋白胨和牛肉膏粉提供碳源、氮源、维生素和矿物质;较高含量的氯化钠提供较高的渗透压,抑制大多数非葡萄球菌的微生物。
2.Baird-Parker 琼脂基础
胰蛋白胨、牛肉膏粉和酵母膏粉提供碳氮源、维生素和生长因子 ;丙酮酸钠和甘氨酸刺激葡萄球菌的生长 ;氯化锂和亚碲酸钾抑制非葡萄球菌的微生物 ;含有卵磷脂酶的葡萄球菌降解卵黄使菌落产生透明圈,而脂酶作用则产生不透明的沉淀环 ;凝固酶阳性的葡萄球菌还能还原亚碲酸钾而产生黑色菌落 ;琼脂是培养基的凝固剂。
3. 血琼脂平板
酪蛋白胰酶消化物、心胰酶消化物、肉胃酶消化物、酵母浸出粉、可溶性淀粉提供碳氮源、维生素和生长因子 ;羊血是细菌生长繁殖的良好营养物质。在 45 ~ 50℃的基础培养基中加入血液可以保存血液中某些不耐热的生长因子,同时血球不被破坏。
4. 脑心浸出液肉汤(BHI)
胰蛋白质胨和牛心浸出液提供氮源、维生素和生长因子 ;葡萄糖可为多种细菌提供能源 ;氯化钠维持均衡的渗透压 ;磷酸氢二钠为缓冲剂。

7.5% 氯化钠肉汤验证
1、产品用途 :用于金黄色葡萄球菌和其它耐盐菌的选择性增菌培养。
2、检验原理 :蛋白胨和牛肉膏粉提供碳源、氮源、维生素和矿物质 ;较高含量的氯化钠提供较高的渗透压,抑制大多数非葡萄球菌的微生物。
3、7.5% 氯化钠肉汤验证

4、典型特征图片 :

5、验证结果小结 :
1、生长率 :目标菌金黄色葡萄球 ATCC6538, L 品牌、 H 品牌、逗点均满足国标在 Baird-Parker 上> 10Cfu, 菌落黑色凸起,周围有一混浊带,在其外层有一透明圈的要求
2、选择性 :大肠埃希氏菌 ATCC25922, L 品牌、 H 品牌、逗点均符合国标在 TSA 上< 100Cfu 要求。
3、感观 :三家产品外观颜色无明显差异。
Baird-Parker 琼脂验证
1、产品用途 :用于凝固酶阳性葡萄球菌的选择性分离培养和计数。
2、检验原理 :胰蛋白胨、牛肉膏粉和酵母膏粉提供碳氮源、维生素和生长因子 ;丙酮酸钠和甘氨酸刺激葡萄球菌的生长 ;氯化锂和亚碲酸钾抑制非葡萄球菌的微生物 ;含有卵磷脂酶的葡萄球菌降解卵黄使菌落产生透明圈,而脂酶作用则产生不透明的沉淀环 ;凝固酶阳性的葡萄球菌还能还原亚碲酸钾而产生黑色菌落 ;琼脂是培养基的凝固剂。
3、Baird-Parker 琼脂验证

4、典型特征图片 :

5、验证结果小结 :
1、生长率 :目标菌金黄色葡萄球菌 ATCC6538,逗点、L 品牌、H 品牌均满足 PR ≥ 0.7 的要求 ;
2、特异性 :表皮葡萄球菌 ATCC12228,逗点、H 品牌、L 品牌符合黑色菌落,无混浊带和透明圈的要求 ;
3、选择性 :大肠埃希氏菌 ATCC25922,逗点、L 品牌、H 品牌符合 G ≤ 1 的要求 ;
4、感观 :三家平板颜色无显著差异。
血液琼脂基础验证
1. 产品用途 :加入脱纤维羊血或兔血,制成血琼脂培养基,用于营养要求较高的
细菌的培养及溶血试验。
2. 检验原理:蛋白胨提供碳氮源、维生素和生长因子;氯化钠维持均衡的渗透压;琼脂是培养基的凝固剂。
3. 血液琼脂基础验证

4、验证结果小结
1. 特异性 :目标菌金黄色葡萄球菌 ATCC 6538、蜡样芽胞杆菌 CMCC(B)63303,逗点、L 品牌、H 品牌均满足国标生长特性溶血现象的要求,逗点、H 品牌溶血现象明显,L 品牌溶血现象较弱。逗点生长速度较缓慢。
2. 感观 :逗点、L 品牌、H 品牌外观颜色无明显差异。
脑心浸出液肉汤(BHI)
1、产品用途:用于霉菌、酵母、细菌的培养,包括营养要求较高的微生物的培养,特别用于食品微生物检验中金黄色葡萄球菌的纯培养。
2、检验原理 :胰蛋白质胨和牛心浸出液提供氮源、维生素和生长因子 ;葡萄糖可为多种细菌提供能源 ;氯化钠维持均衡的渗透压 ;磷酸氢二钠为缓冲剂。
3、脑心浸出液肉汤(BHI) 验证数据

4、典型特征图片 :
5、验证结果小结 :
1. 生长率 :目标菌金黄色葡萄球 ATCC6538 逗点、L 品牌、H 品牌的混浊度满足要求 ;
2. 感观 :逗点的液体颜色较深,L 品牌颜色较淡,H 品牌颜色在两家之间。
3. 都满足标准,液体增菌仅看外观,并不能发现明显差别。